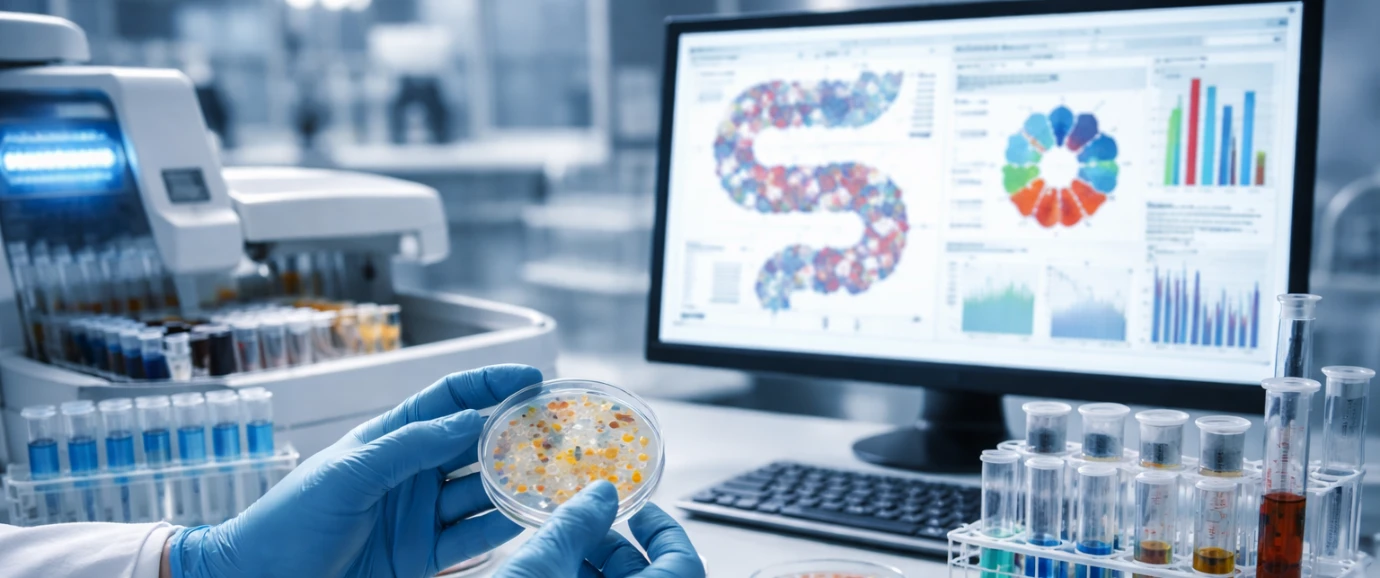

Lácteos y derivados
La startup Biotasmart levanta una ronda histórica y pone el foco en la microbiota y nutrición personalizada
Esta inversión ofrece nuevas oportunidades para la industria de A&B, alineadas con tendencias de bienestar, personalización y prevención

Redacción THE FOOD TECH
Equipo editorial de contenidos
Última actualización:
Newsletter
Lo último

